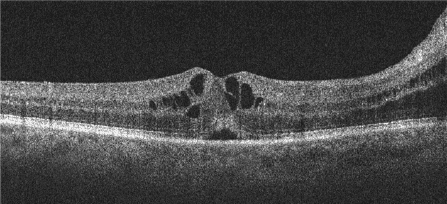
figure 4 spill over from disc edema

Lessons on Juxtapapillary Fluid
Fluid around the optic nerve can be alarming, but not all juxtapapillary fluid is the same. When present, the primary focus of the comprehensive medical eyecare provider should be to determine the source of the juxtapapillary fluid, if possible, and accurately triage its threat, thus leading to appropriate management or referral. Some juxtapapillary fluid is low risk and can be monitored; others require urgent workup, referral or intervention. Various sources of juxtapapillary fluid will be discussed to examine why juxtapapillary fluid may be present.
Â
Cavitary Disc Malformations
Intraretinal or Subretinal Fluid
Developmental optic disc malformations such as optic disc pits, colobomas, morning glory discs or juxtapapillary cavitations—collectively known as cavitary anomalies—predispose the eye to juxtapapillary intraretinal (IRF) and/or subretinal fluid (SRF). Anomalous pathways between the exterior and interior of the eye due to defects in the lamina cribrosa or sclera in the juxtapapillary zone allow for cerebrospinal (CSF) or vitreous fluid to permeate the juxtapapillary retinal tissue or, occasionally, the subretinal space in these conditions.1
The optic nerve has CSF within its sheath, and this space abuts the optic nerve head opening in the posterior globe; cavitary disc anomalies, however, may allow abnormal access of this subarachnoid space into the eye. Furthermore, as dysplastic tissue at the disc herniates posteriorly into the anomalous cavitation, gaps in the tissue may allow vitreous anomalous posterior channels into the retina or subretinal space. Alterations of the translaminar CSF pressure versus intraocular pressure (IOP) gradient (i.e., intracranial pressure (ICP) versus IOP) enable pathologic fluid flow into or under the retina next to the disc.1 This fluid may be vitreous or CSF, depending on the pressure gradient, which will dictate the direction of fluid flow.
Due to their proximity, this fluid affects the local juxtapapillary retina and may extend to the macula, often leading to serous detachments or schisis-like IRF in the macula (Figure 1).1 The fluid within the retina typically communicates directly with the optic disc’s anomalous cavitation. In contrast, any subretinal fluid usually does not, but instead, seeps into the subretinal space via a subclinical microbreak in the outer retina.1 Recall that serous fluid looks optically empty on optical coherence tomography (OCT), which is the case in the fluid seen here.

Figure 1. Optic disc pit with retinoschisis-like IRF extending into the macula, communicating directly with the disc’s anomalous cavitation. This patient also developed juxtapapillary CNV with juxtapapillary subretinal fluid surrounding early subretinal fibrosis.
Over half of the cases with optic disc pits develop serous maculopathy, and almost two-thirds of those whose pits are located temporally.2 Visual outcomes are very poor in untreated cavitary disc maculopathy—reported by Sobol et al. at 20/200 or worse in 80%.3
Intervention from a retinal specialist is required when disc anomalies allow the translaminar pressure gradient to introduce intraretinal or subretinal fluid. Careful photocoagulation adjacent to the disc to barricade the fluid highway immediately followed by vitrectomy with gas tamponade to deal with the translaminar pressure gradient is just one way to address the pathophysiologic mechanism of the maculopathy associated with these disc anomalies (many other treatments have been tried with variable success).1,4
Juxtapapillary Choroidal Neovascularization
Intraretinal or Subretinal Fluid or HemorrhageÂ
Fluid around the disc may also be related to choroidal neovascularization (CNV), which may cause SRF, IRF, hemorrhage and/or exudate. Whereas the serous aspects of fluid appear optically empty, hemorrhage appears more hyperreflective and heterogenous by OCT, and exudate is very hyperreflective (Figure 2).

Figure 2. Upper Panel: Juxtapapillary SRF with hemorrhagic pigment epithelial detachment and modest overlying subretinal hemorrhage due to CNV. Lower Panel: Juxtapapillary SRF with mid-retinal exudates due to CNV.
Disruptions in Bruch’s Membrane (BM) or the RPE adjacent to the disc predispose that area to CNV formation risk. Juxtapapillary angioid streaks are a great example, where cracks in BM are potential entry points for CNV. Additional conditions at or around the optic disc also are risk factors for juxtapapillary CNV, such as the pachychoroid spectrum of diseases, juxtapapillary tumors (infectious, inflammatory, infiltrative, neoplastic), peripapillary atrophy or scarring or even optic disc drusen. Juxtapapillary CNV may also be idiopathic, especially in older patients—in this cohort, there may be a high risk for the development of a similar lesion in the same location of the fellow eye.5
Treatment of juxtapapillary CNV will depend on several factors: What (if any) underlying condition is associated with the CNV formation? Clearly, any known underlying issue needs to be addressed when possible. Is this juxtapapillary CNV threatening the macula? The Macular Photocoagulation Study Group found that 26% of untreated peripapillary CNV with juxtafoveal involvement led to significant vision loss at three years—ultimately due to foveal scarring or atrophy.6 How large is the affected area, and on which side of the disc is it located? Is the patient symptomatic? Is the patient reliable to follow up? As in CNV elsewhere, treatment options largely boil down to laser photocoagulation, photodynamic therapy (PDT) with verteporfin, intravitreal injections of anti-VEGF agents, or monitoring without intervention.
Laser photocoagulation is an effective treatment, though sometimes must be repeated due to poorly defined CNV margins or recurrent vessel growth.5 Because of the proximity to the optic disc, the resultant scotoma from laser photocoagulation largely borders the normal blind spot, so it often does not produce patient symptoms, depending on the area treated. Remember that laser scars expand6 and may cause functional vision loss due to inadvertent thermal injury to the optic nerve or the overlying papillomacular bundle,7 so juxtapapillary CNV are generally not laser-eligible unless at least 1.5 clock hours of the temporal disc would be spared.6Â In cases like this, PDT or anti-VEGF injections may instead be employed.7,8
Notably, monitoring the natural progression of juxtapapillary CNV is sometimes a reasonable consideration.7 The endgame of CNV is chorioretinal atrophy and scarring, often with subretinal fibrosis. Is this ever acceptable? This may be sensible for juxtapapillary CNV that are, for example, asymptomatic, not associated with an underlying condition that needs treatment, affecting only a very small area on a lower-risk aspect of the disc, and are not threatening the macula. However, bear in mind that subretinal vascular complexes may proliferate, even after treatment.5
Several factors must be considered when deciding whether to refer or closely monitor juxtapapillary CNV. One is your capability to keep a close watch: patients will need frequent exams, so your clinic schedule must be accommodating; also, adequate monitoring is essentially impossible without OCT (and OCT-Angiography is extremely helpful). If you are not equipped, then refer. A second factor is the accessibility to a retinal specialist; if the findings worsen and you cannot ensure a patient will be able to get into a retinal specialist’s care very quickly, then they should be under the retinal specialist’s care before things deteriorate. Another consideration is your understanding of these conditions and your own ability and comfort in managing these patients. Don’t be overconfident to your patient’s detriment, and remember that referring the patient to a retinal specialist is never wrong.
Incomplete Retinal Conforming
Not Fluid
Disc anomalies like peripapillary atrophy and juxtapapillary staphylomas may also be the culprit for a draping-type phenomenon adjacent to the disc, which may mimic SRF. These conditions need to be differentiated as the management differs. When there is a relatively abrupt change in topography adjacent to the disc, the retina may not conform precisely to the staphyloma contour but instead drape over the lower point, allowing some intraretinal stretching and leaving irregular open spaces with the appearance of IRF and/or SRF. This incomplete retinal conforming is akin to how the retina often drapes over areas of focal choroidal excavations. This does not require intervention but typically requires fluorescein angiography (FA) as the most helpful tool to differentiate draping from actual SRF (Figure 3), which may exist due to associated CNV or even from retinal detachment—more likely in cases where cavitary disc malformations such as optic disc pits or colobomas co-exist with the posterior staphyloma.9
Similarly, the loss of sections of the retina due to atrophy from a variety of conditions creates more space—essentially a decompression of the retinal tissue. This leads to the rest of the retina to either stretch to fill the gaps, leaving a retinoschisis-like cavity, or to somewhat collapse and conform, potentially leaving pockets that may appear like SRF or IRF on OCT.

Figure 3. Upper Panel: Incomplete Retinal Conforming phenomenon with some adjacent retinoschisis on the nasal disc margin in a high myope with posterior staphyloma. Lower Panel: Fluorescein angiography indicates a window defect around the optic nerve but no hyperfluorescence consistent with CNV. In this case, FA was crucial for diagnosis, given the somewhat atypical draping.
Optic Disc edema
Spill-Over Intraretinal or Subretinal Fluid
Juxtapapillary fluid can also be present due to the countless causes of optic disc edema: papilledema, infectious, inflammatory, ischemic, compressive causes…the list goes on. We will not discuss differentiating the underlying cause as to why the disc is edematous. Still, with it, we primarily see edematous thickening of the nerve fiber layer (NFL) itself at and adjacent to the disc, as well as vasogenic spill-over IRF or SRF (Figure 4). When there is impeded axonal transport (e.g., increased ICP, ischemia, etc) within the retinal ganglion cell axons (eg NFL), the axons swell, and intra-axonal fluid and cellular contents expel from the axons. Subsequently, the regional venules, whose low-pressure flow is easily overcome by the local edema’s compression, will leak due to this venous stasis and reduced perfusion. Clinically, these are evident as optic disc edema and extracellular fluid collections (e.g., IRF or SRF).10-12 In these cases, the juxtapapillary IRF or SRF will generally resolve with treatment/resolution of the underlying cause of the optic disc edema.
Vitreopapillary Traction
Tractional, Intraretinal or Subretinal Fluid, Hemorrhage or Retinoschisis Cavity
Vitreopapillary traction (VPT) from adherent vitreous tugging on the disc may lead to juxtapapillary fluid, hemorrhages (intra- or subretinal), or tractional retinoschisis of the juxtapapillary retina. VPT is typically seen due to incomplete posterior vitreous detachment (PVD) but may also be seen in high myopes or dysplastic discs13—likely due to an abnormal relationship between the disc and vitreous in these eyes. VPT may also, though rarely, cause vitreopapillary traction optic neuropathy (VPTON), where the traction may actually reduce axoplasmic flow, reducing disc perfusion and inducing ischemic disc edema14 and subsequent pallor upon resolution. As we know, VPT tends to self-resolve with PVD and the juxtapapillary fluid or retinoschisis along with it. In some cases, however, such as in VPTON, when significant symptoms occur, or there is a concern for the adjacent retina/macula, a vitreoretinal surgeon should be consulted to consider surgical PVD/vitrectomy.
Peripapillary Retinoschisis
Retinoschisis Cavity
Peripapillary retinoschisis (PRS) (with or without macular retinoschisis) may be seen in high myopia, and the cavitary disc malformations or VPT discussed above, but also may be found in association with other conditions. PRS has been associated with various types of both primary and secondary advanced glaucomas.15 Several theories on the exact mechanism of this correlation have been proposed, including defects in the lamina cribrosa,16 or vitreous interaction with weakened RNFL and Müeller cell structure, with factors such as increased- or flux in IOP likely contributing.17 PRS in glaucoma may self-resolve18 and is usually only problematic if the macula is affected.
Conclusion
Fluid around the optic disc can come from a variety of sources. Thorough clinical exam and accurate interpretation of ancillary studies, such as OCT or FA, are crucial in differentiating these etiologies and appropriately managing patients.
References:
- Nieraj J, Johnson MW. Pathogenesis and treatment of maculopathy associated with cavitary optic disc anomalies. Am J Ophthalmol. 2014 Sep;158(3):423-353.
- Brown GC, Shields JA, Goldberg RE. Congenital Pits of the Optic Nerve Head: II. Clinical Studies in Humans. Ophthalmology. 1980 Jan;87(1):51-65.
- Sobol WM, Blodi CF, Folk JC, Weingeist TA. Long-term visual outcome in patients with optic nerve pit and serous retinal detachment of the macula. Ophthalmology. 1990;97(11):1539-42.
- Kiang L, Johnson MW. Formation of an Intraretinal Fluid Barrier in Cavitary Optic Disc Maculopathy. Am J Ophthalmol. 2017 Jan;173:34-44.
- Kies JC, Bird AC. Juxtapapillary Choroidal Neovascularization in Older Patients. Am J Ophthalmol. 1988 Jan;105(1):11-19.
- Laser photocoagulation for neovascular lesions nasal to the fovea. Results from clinical trials for lesions secondary to ocular histoplasmosis or idiopathic causes. Macular Photocoagulation Study Group. Arch Ophthalmol. 1995 Jan;113(1):56-61
- Rosenblatt B, Shah GK, Blinder K. Photodynamic therapy with verteporfin for peripapillary choroidal neovascularization. Retina. 2005 Jan;25(1):33-7.
- Cakir M, Cekiç O, Yilmaz OF. Intravitreal bevacizumab for idiopathic choroidal neovascularization. J AAPOS. 2009 Jun;13(3):296-8.
- Okano K, Ishida T, Inoue M, Hirakata A. Retinal detachment and retinoschisis associated with optic disc pit in peripapillary staphyloma. Am J Ophth Case Rep. 2022;26:101468.
- Hayreh SS. Pathogenesis of optic disc edema in raised intracranial pressure. Prog Retin Eye Res. 2016 Jan;50:108-44.
- Reier L, Fowler JB, Arshad M, Hadi H, et al. Optic Disc Edema and Elevated Intracranial Pressure (ICP): A Comprehensive Review of Papilledema. Cureus. 2022 May;14(5):e24915.
- Tawse KL, Hedges TR III, Gobuty M, Mendoza-Santiesteban C. Optical coherence tomography shows retinal abnormalities associated with optic nerve disease. Br J Ophthalmol. 2014 Jul;98(suppl2):ii30-ii33.
- Katz B, Hoyt WF. Intrapapillary and Peripapillary Hemorrhage in Young Patients with Incomplete Posterior Vitreous Detachment, Signs of Vitreopapillary Traction. Ophthalmol. 1995;102(2):349-54.
- Weng CY, Khimani KS, Foroozan R, Cospe SM III, Bhatti MT. A Sticky Situation. Surv Ophthalmol. 201;63;736-44.
- Young B, Munoz M, Soto EM. Peripapillary Retinoschisis in a Patient with Severe Primary Open Angle Glaucoma. J Med Optom. 2023 May.
- Lee JH, Park HYL, Baek J, Lee WK. Alterations of the lamina cribrosa are associated with peripapillary retinoschisis in glaucoma and pachychoroid spectrum disease. Ophthalmology. 2016;123(10):2066–76.
- Nishijima R, Ogawa S, Nishijima E, Itoh Y, et al. Factors Determining the Morphology of Peripapillary Retinoschisis. Clin Ophthalmol. 2021;15:1293-1300.
- Kahook MY, Noecker RJ, Ishikawa H, Wollstein G, Kagemann L, Wojtkowski M, et al. Peripapillary schisis in glaucoma patients with narrow angles and increased intraocular pressure. Am J Ophthalmol. 2007;143(4):697–9.
Dr. Weidmayer graduated from the Michigan College of Optometry and completed her ocular disease residency at the Battle Creek VA Medical Center in Battle Creek, MI. She practices at the LTC Charles S. Kettles VA Medical Center in Ann Arbor, MI. She is also a Clinical Associate Professor for the Department of Ophthalmology and Visual Sciences, Kellogg Eye Center, University of Michigan.